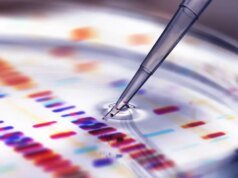
Por que os cientistas não conseguem rir

A Apple e a Sydney Opera House, na Austrália, anunciaram recentemente uma colaboração, e acontece que isso estará relacionado às comemorações do 50º aniversário da Apple.
Em sua página do Instagram no início desta semana, o compositor australiano Bailey Pickles disse A Apple pediu que ele compusesse e tocasse músicas para a celebração do 50º aniversário na Ópera, onde a Apple em breve iluminará obras de arte.
De 25 a 27 de março, as velas orientais da Opera House serão iluminadas com obras de arte criadas no aplicativo Procreate no iPad por um grupo de 10 artistas australianos emergentes. Por meio de sessões gratuitas do Today at Apple no início deste mês, o público também teve a oportunidade de criar e enviar obras de arte para potencial iluminação.
A Apple disse que as obras de arte selecionadas de artistas comissionados e submissões públicas serão selecionadas e projetadas nas velas orientais da Opera House em 25 de março às 20h30, horário local, e em 26 e 27 de março, às 20h, horário local. Pickles não disse exatamente quando se apresentará no local mundialmente famoso, mas está claro que a celebração do 50º aniversário envolverá uma mistura de arte e música.
Não está claro se o CEO da Apple, Tim Cook, ou qualquer outro executivo da empresa comparecerá a esta celebração, mas é importante notar que Cook está atualmente na China, então ele está muito mais perto da Austrália agora do que normalmente estaria. Talvez ele faça uma aparição surpresa na Opera House em algum momento, mas só o tempo dirá.
A Apple já organizou comemorações do 50º aniversário nos Estados Unidos, China e Coreia do Sul até agora, com mais comemorações no Canadá, França e Tailândia, além da Austrália. Nosso palpite é que a Apple eventualmente realizará uma celebração final na Califórnia – os arcos de arco-íris dentro do Apple Park seriam o local perfeito para uma última reunião.
A Apple completa 50 anos em 1º de abril.